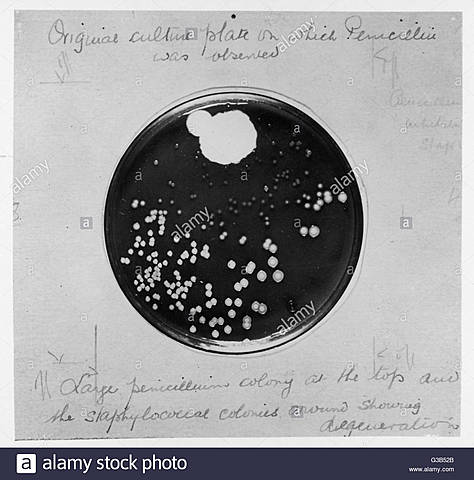
Discovery of Penicillin, First discovered.

-
Prosthetics were originally made from wood and peg during the Dark ages. But Gustav Hermann came up with the concept to make them from Aluminium and having suction points instead of sleeves. This was because Aluminium is able to withstand a longer amount of time as the previous prosthetics using wood and peg can easily split and rot.
-
After Gustav came up with the concept of the Aluminium prosthetic, in 1912, Marcel Desoutter and his brother Charles developed the first physical Prosthetic made from aluminium. The Prosthetic made was a leg for Marcel as he sadly lost his leg in an airplane accident. This was the first ever prosthetic limb made out of the sturdy but light material of Aluminium.
-
In 1925, the first attempt to replace an elbow joint by prosthetic materials was documented, when a doctor inserted an anatomically correct elbow prosthesis, consisting of metal and hardened rubber.
-
Penicillin was first discovered by Alexander Flemming in his laboratory when he found an open petri dish that has originally had Staphylococcus bacteria inside. But the Petri dish now contained a new substance, a blue-green mold had grown on top of the original bacteria. After many tests and research Alexander found that this new substance that had grown in his petri dish was the undiscovered Penicillin.
-
The main scientists were, Howard Florey, Norman Heatley and Ernst Chain. They ran many tests and experiments with the new found drug, in March 1940 the drug was tested on 2 Mice, injected into them to test if the drug would pass the 'Toxicity test'. The mice were reportedly un harmed during these experiments.
The Penicillin itself went through 14 years of discovery and development before it was ready to use for its intended purpose. -
In 1941, another doctor used a hinged non-anatomical prosthesis completely made of metal
-
Anne Miller needed the Penicillin as after a miscarriage she unfortunately developed a severe infection known as blood poisoning that in turn became life threatening. A blood transfusion had been preformed previously and not worked or cured her, She had a fever of 103 degrees. She was administered with the new Penicillin drug and within a day her fever was back in a normal range, she had be cured as such. This was the first successful dosage of the Penicillin drug. First recorded patient.
-
The first ever kidney transplant happened in Boston at the Peter Bent Brigham Hospital between Ronald Hendrik who gave one of his kidneys to his twin brother Richard because he had chronic kidney failure. The transplant was executed by Dr Joeseph E. Murray and his colleges
-
In the early 1960s Sir John Charnley inspired development of the Condylar knee replacement.
-
The first CT scanner was by made by both Godfrey Houndsfield and Allan Cormack during 1967. Over 2 years they built a scanner that could scan any body part and produce a cross sectional image that basically shows the inside of their body without having to cut them open to look at. The image is used by doctors to see if there is an issue inside the human body, and if there is, where it is precisely located so they can be as accurate as possible when doing surgeries.
-
A 58 year old male sentenced to Death Row was admitted to the University of Mississippi Medical Centre. He had a history of productive cough, bronchitis and shortness of breath. A bronchoscope biopsy confirmed a skin cancer tumour on the left main bronchus. In addition to this the patient also had chronic renal disease (which he had been treated for) and azotemia.
-
Dr. James Hardy and his medical team performed the first lung transplant on a convicted murder who was sentenced to life in prison. The procedure was successful.
-
Patient died 18 days after surgery from renal failure with no evidence of rejection of the transplanted lung in the postmortem exam.
-
This was the first time a patient had woken up from a heart transplant surgery
-
Dr. Gunston who worked with Sir John Charnley went on to implant the first polycentric knee with an unhinged knee design which replaced both the medial and lateral sides, therefore making it the first total knee replacement. This implant was designed to be a game changer for patients with arthritis where other medicine approaches such as physio therapy had failed. The implant recreated how real knees worked and was the first one to contain all the correct anatomically shaped parts in the knee.
-
The First recorded brain scan using the CT scanner was done in Atkinson Morley Hospital, Wimbledon, England. The scan took just over 5 minutes to complete, but the processing of the image took a little over 2.5 hours to be used by doctors.
-
After the first successful CT scan was produced in 1971, they were happy and confident enough to announce to the world their new creation of the CT scanner.
-
Dr. Dee designed the first functional TEA in 1972. This initiated an increase in various TEA models throughout the 1970’s. Designing a TEA is a very difficult task as it has to copy the native function and stability of all three articulations in the elbow joint. TEA considerably improves the upper limb and increases the quality of life. This is why it is a great option for people who suffer from a decreased range of motion in their elbow caused by primary osteoarthritis or trauma.
-
This was the first time that twins conjoined at the head had survived the operation to separate them.
-
This was the first time that a living donor had been used in a liver transplant.
-
After a prison brawl that happened in 1984, Clint Hallam lost his right hand. Professor Nadey Hakim had a past working with patients in difficult and complicated situations. In 1998 he worked alongside his team of different surgeons coming from around the world to work with Clint after then found he was a suitable patient to surgically remove the hand from a brain dead patient and insert onto Clint
-
Isabelle Dino suffered from a dog attack in May 2005 and struggled to talk and eat. The facial organs were taken from a brain dead patient, consent coming from the patient's family. The surgery was very intricate because it was dealing with work around the mouth, nose and cheekbone area. It was performed in Aimes and then Isabelle was moved to another hospital in Lyon. After the surgery was completed, the patient was reportedly in “excellent" condition.
Looking for a timeline maker?
Create timelines for projects, roadmaps, history, lessons, legal cases, and stories with Timetoast. Timetoast is a timeline maker for work, school, research, and stories.